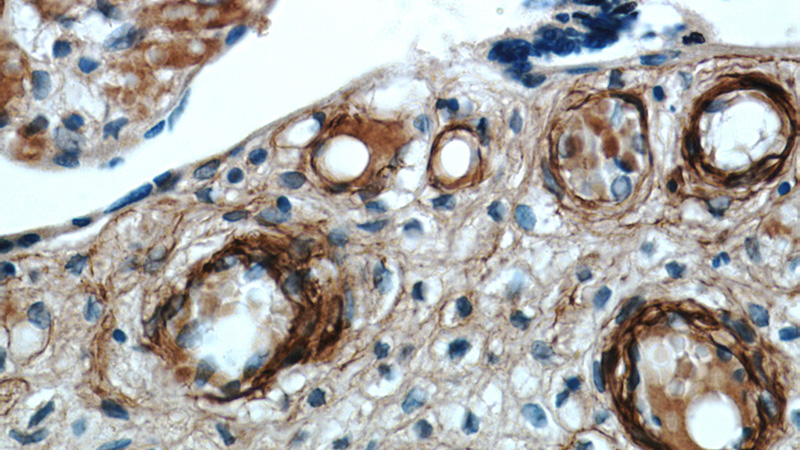
Immunohistochemical of paraffin-embedded human placenta using Catalog No:116735(VEGFA antibody) at dilution of 1:50 (under 40x lens)

-
Product Name
VEGF antibody
- Documents
-
Description
VEGF Rabbit Polyclonal antibody. Positive IHC detected in human placenta tissue, human colon cancer tissue, human liver cancer tissue. Positive IF detected in HepG2 cells. Positive WB detected in PC-3 cells, A431 cells, HepG2 cells, Jurkat cells, MCF7 cells. Positive IP detected in MCF-7 cells. Observed molecular weight by Western-blot: 23-27 kDa,45 kDa
-
Tested applications
ELISA, IHC, IF, IP, WB
-
Species reactivity
Human,Mouse,Rat; other species not tested.
-
Alternative names
L VEGFA antibody; MVCD1 antibody; Vascular permeability factor antibody; VEGF antibody; VEGF A antibody; VEGFA antibody; VPF antibody
-
Isotype
Rabbit IgG
-
Preparation
This antibody was obtained by immunization of VEGF recombinant protein (Accession Number: BC065522). Purification method: Antigen affinity purified.
-
Clonality
Polyclonal
-
Formulation
PBS with 0.02% sodium azide and 50% glycerol pH 7.3.
-
Storage instructions
Store at -20℃. DO NOT ALIQUOT
-
Applications
Recommended Dilution:
WB: 1:200-1:2000
IP: 1:200-1:2000
IHC: 1:20-1:200
IF: 1:10-1:100
-
Validations

PC-3 cells were subjected to SDS PAGE followed by western blot with Catalog No:116735(VEGFA antibody) at dilution of 1:800

IP Result of anti-VEGFA (IP:Catalog No:116735, 3ug; Detection:Catalog No:116735 1:500) with MCF-7 cells lysate 2500ug.

Immunohistochemical of paraffin-embedded human placenta using Catalog No:116735(VEGFA antibody) at dilution of 1:50 (under 10x lens)
Immunohistochemical of paraffin-embedded human placenta using Catalog No:116735(VEGFA antibody) at dilution of 1:50 (under 40x lens)

Immunofluorescent analysis of HepG2 cells, using VEGFA antibody Catalog No:116735 at 1:25 dilution and Rhodamine-labeled goat anti-rabbit IgG (red).
-
Background
VEGFA, also named as VEGF or VPF, belongs to the PDGF/VEGF growth factor family. It is a growth factor active in angiogenesis, vasculogenesis and endothelial cell growth. VEGFA induces endothelial cell proliferation, promotes cell migration, inhibits apoptosis and induces permeabilization of blood vessels. It binds to the FLT1/VEGFR1 and KDR/VEGFR2 receptors, heparan sulfate and heparin. Defects in VEGFA are a cause of susceptibility to microvascular complications of diabetes type 1 (MVCD1). VEGFA has 13 isoforms with MW 16kd to 45kd. Some isoforms has homodimer form, such as VEGFA189(38kd), VEFGA110(34kd). VEGFA is a 34kd to 42kd, dimeric, disulfide-bound glycoprotein. VEGF-A exists in at least seven homodimeric isoforms. The monomers consist of 121, 145, 148, 165, 183, 189, or 206 amino acids(PMID:15602010 ). This antibody can recognize all the isoforms of VEFGA.
-
References
- Shan X, Wang D, Chen J. Necrosis degree displayed in computed tomography images correlated with hypoxia and angiogenesis in breast cancer. Journal of computer assisted tomography. 37(1):22-8. 2013.
- Zhou B, Ma R, Si W. MicroRNA-503 targets FGF2 and VEGFA and inhibits tumor angiogenesis and growth. Cancer letters. 333(2):159-69. 2013.
- Song G, Li Y, Zhang Z. c-myc but not Hif-1α-dependent downregulation of VEGF influences the proliferation and differentiation of HL-60 cells induced by ATRA. Oncology reports. 29(6):2378-84. 2013.
- Chai L, Ling K, He X, Yang R. Expression of ATF4 and VEGF in chorionic villus tissue in early spontaneous abortion. European journal of obstetrics, gynecology, and reproductive biology. 170(2):434-8. 2013.
- Li D, Han Z, Liu J. Upregulation of nucleus HDGF predicts poor prognostic outcome in patients with penile squamous cell carcinoma bypass VEGF-A and Ki-67. Medical oncology (Northwood, London, England). 30(4):702. 2013.
- Balakrishnan I, Yang X, Brown J. Genome-wide analysis of miRNA-mRNA interactions in marrow stromal cells. Stem cells (Dayton, Ohio). 32(3):662-73. 2014.
- Bai WW, Xing YF, Wang B. Tongxinluo Improves Cardiac Function and Ameliorates Ventricular Remodeling in Mice Model of Myocardial Infarction through Enhancing Angiogenesis. Evidence-based complementary and alternative medicine : eCAM. 2013:813247. 2013.
- Liu F, You X, Wang Y. The oncoprotein HBXIP enhances angiogenesis and growth of breast cancer through modulating FGF8 and VEGF. Carcinogenesis. 35(5):1144-53. 2014.
Related Products / Services
Please note: All products are "FOR RESEARCH USE ONLY AND ARE NOT INTENDED FOR DIAGNOSTIC OR THERAPEUTIC USE"
